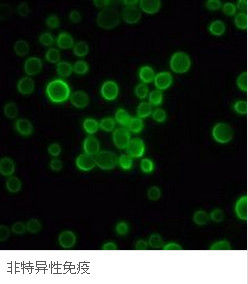
1

分類
固有免疫(非特異性免疫)系統分類
固有免疫(非特異性免疫)系統包括:組織屏障(皮膚和黏膜系統、血腦屏障、胎盤屏障等);固有免疫細胞(吞噬細胞、殺傷細胞、樹突狀細胞等);固有免疫分子(補體、細胞因子、酶類物質等)。
特點
非特異性免疫
非特異性免疫②反應快。抗原物質一旦接觸機體,立即遭到機體的排斥和清除。
③有相對的穩定性。既不受入侵抗原物質的影響,也不因入侵抗原物質的強弱或次數而有所增減。但是,當機體受到共同抗原或佐劑的作用時,也可增強免疫的能力。
④有遺傳性。生物體出生後即具有非特異性免疫能力,並能遺傳給後代。因此,非特異性免疫又稱先天性免疫或物種免疫。
⑤是特異性免疫發展的基礎。從種系發育來看,無脊椎動物的免疫都是非特異性的,脊椎動物除非特異性免疫外,還發展了特異性免疫,兩者緊密結合,不能截然分開。從個體發育來看,當抗原物質入侵機體以後,首先發揮作用的是非特異性免疫,而後產生特異性免疫。因此,非特異性免疫是一切免疫防護能力的基礎。
功能
發揮保護功能的幾道屏障 首先是外圍屏障。皮膚黏膜是機體第一道防線,包括:皮膚黏膜的機械阻擋作用和附屬物(如纖毛)的清除作用;皮膚黏膜分泌物(如汗腺分泌的乳酸、胃黏膜分泌的胃酸等)的殺菌作用;體表和與外界相通的腔道中寄居的正常微生物叢對入侵微生物的拮抗作用等。其次是內部屏障。抗原物質一旦突破第一道防線進入機體後,即遭到機體內部屏障的清除,包括:淋巴和單核吞噬細胞系統屏障;正常體液中的一些非特異性殺菌物質;血腦屏障和胎盤屏障等。
①淋巴和單核吞噬細胞系統是機體的第二道防線。微生物進入機體組織以後,多數沿組織細胞間隙的淋巴液經淋巴管到達淋巴結,但淋巴結內的巨噬細胞會消滅它們,阻止它們在機體內擴散,這就是淋巴屏障作用。如果微生物數量大,毒力強,就有可能衝破淋巴屏障,進入血液循環,擴散到組織器官中去。這時,它們會受到單核吞噬細胞系統屏障的阻擋。這是一類大的吞噬細胞。機體內還有一類較小的吞噬細胞,其中主要的是中性粒細胞和嗜酸性粒細胞。它們不屬於單核吞噬細胞系統,但與單核吞噬細胞系統一樣,分布於全身,對入侵的微生物和大分子物質有吞噬、消化和消除的作用。
②在正常體液中的一些非特異性殺菌物質,如補體、調理素、溶菌酶、干擾素、乙型溶素、吞噬細胞殺菌素等,也與淋巴和單核吞噬細胞系統屏障一樣,是機體的第二道防線,有助於消滅入侵的微生物。
③血腦屏障主要是由軟腦膜、脈絡膜和腦毛細管組成,可以阻止微生物等侵入腦脊髓和腦膜內,從而保護中樞神經系統不受損害。血腦屏障隨個體發育而逐漸成熟,嬰幼兒容易發生腦脊髓膜炎和腦炎,就是血腦屏障發育不完善的緣故。胎盤屏障是由母體子宮內膜的基蛻膜和胎兒絨毛膜滋養層細胞共同組成的。這個屏障既不妨礙母子間的物質交換,又能防止母體內的病原微生物入侵胎兒,從而保護胎兒的正常發育。
意義
非特異性免疫是特異性免疫的基礎,特異性免疫所產生的免疫物質又能增強非特異性免疫的作用。例如,巨噬細胞吞噬、加工、處理抗原物質,並把抗原傳遞給淋巴細胞,使其產生抗體或淋巴因子,加強殺傷靶細胞的能力。反過來,抗體和淋巴因子的產生也加強了巨噬細胞的趨化、活化和吞噬作用。因此,增強機體的非特異性免疫對提高機體的整個免疫功能意義重大。

